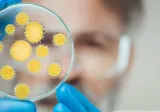
Doctor working in laboratory with a petri dish

Endocrinology at EVMS
- Our specialists include physicians, nurse practitioners and fellows-in-training (as well as your primary care provider), all working together to manage your care.
- Because we are educating the next generation of doctors, your interactions with our medical students and residents helps shape the future of Hampton Roads medical care.
- We provide comprehensive diagnosis, treatment, and management of endocrine disorders, focusing on glands and the hormones they secrete in the body.
We focus on managing:
- Hormone excesses - we work to reduce excessive amounts of any specific hormone.
- Hormone deficiencies - we can provide replacement back to normal levels if there are low levels of a hormone.
- Endocrine gland tumors - if a tumor is present that requires removal, we can refer you to the appropriate surgeon as well as help manage your condition around the time of surgery. We will also monitor you after the operation.